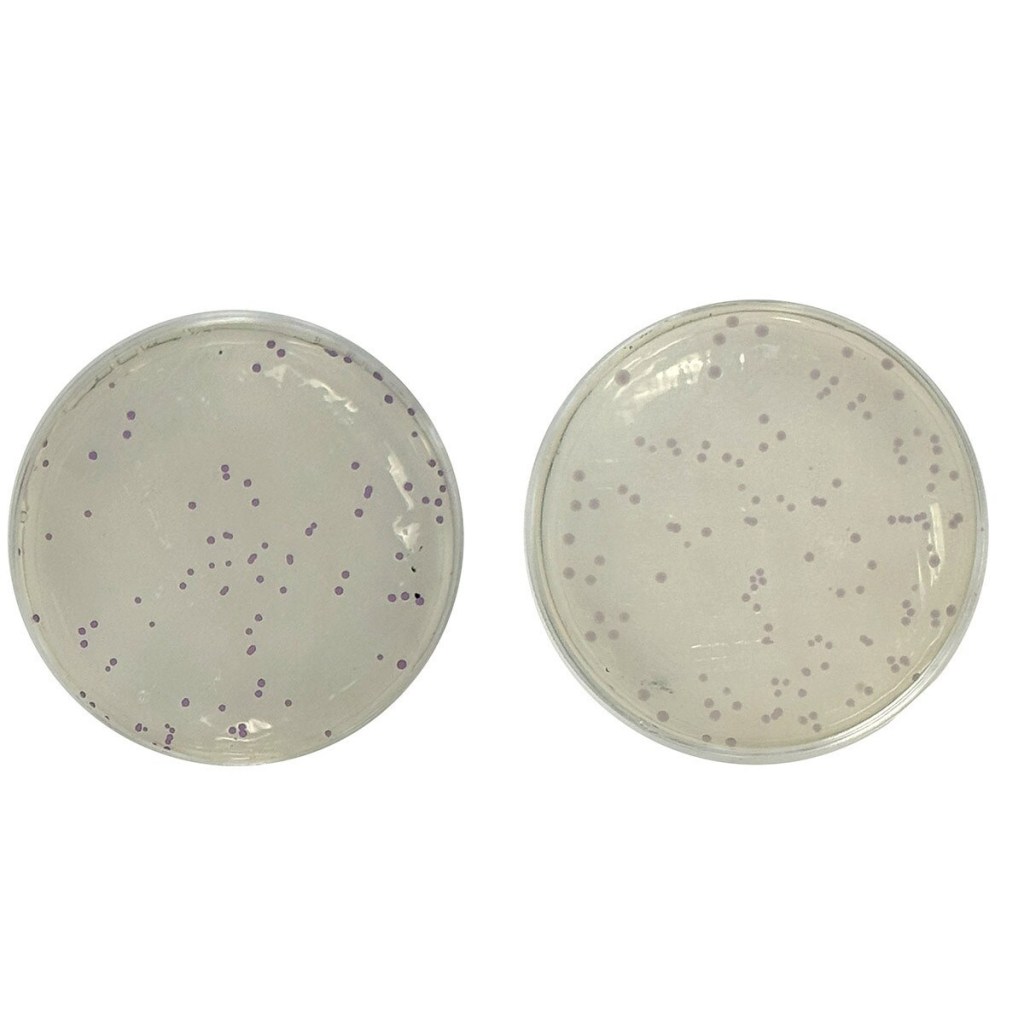

Are you looking for new experiments to change up the hands-on component of your fall courses? Here’s a list of our new offerings! Call or email us if you have any questions — we’d love to help you get these kits in your classroom!

Immune Clues: Diagnosing Allergic Reactions
Take on the role of an allergist to learn how allergies are diagnosed and treated!
In this experiment, students will review a patient’s symptoms and meal history, perform a simulated skin prick allergy test to identify possible triggers, and then use a component-resolved diagnostic simulated blood test to distinguish between a true food allergy and cross-reactivity such as oral allergy syndrome. By analyzing their results, students gain insight into how medical professionals use evidence to guide diagnosis and treatment of allergic reactions.
• Act as an allergist to investigate a patient’s allergic reaction.
• Review the patient’s symptoms, test results, and meal history.
• Perform a simulated skin prick test to check for possible allergens.
• Use a simulated blood allergen testing to confirm if the reaction is a true food allergy or cross-reactivity with pollen.
Fixing Genes, Fighting Disease: A Hands-On CRISPR Lab
This DMD CRISPR Simulation Kit introduces students to gene editing by modeling the correction of a Duchenne Muscular Dystrophy (DMD)-like mutation in bacteria. Using CRISPR-based tools, students restore fluorescence to a mutated GFP gene, simulating therapeutic correction of the dystrophin gene.
The hands-on workflow includes DNA ligation, bacterial transformation, and protein extraction, culminating in SDS-PAGE analysis to visualize gene expression differences. Through this process, students learn how genetic mutations disrupt protein production and how CRISPR can reverse these effects. The experiment emphasizes real-world applications of CRISPR in treating human genetic disorders like DMD, providing both molecular biology skills and disease context. This immersive lab bridges fundamental biotechnology with advanced gene therapy concepts in an accessible and engaging way.
• Demonstrates real-world gene therapy concepts by simulating the correction of a disease-causing mutation using CRISPR, making abstract genetic principles tangible for students.
• Teaches core molecular biology techniques including ligation, transformation, plasmid-based gene expression, protein extraction, and gel electrophoresis.
• Connects biotechnology to human disease by modeling the restoration of dystrophin in Duchenne Muscular Dystrophy, linking lab skills to impactful medical applications.
• Reinforces understanding of CRISPR-Cas9 mechanisms, including guide RNA targeting, PAM site recognition, and DNA repair pathways (NHEJ vs. HDR).
• Promotes inquiry-based learning and data analysis, as students must interpret fluorescence results and protein gel patterns to assess gene correction success.


Precision & Proof: Forensic Biotechnology Skills Training
Step into the role of a forensic investigator with this hands-on activity. Students will explore key techniques used to analyze physical evidence, from fingerprint analysis to blood spatter patterns.
• Practice real forensic methods used in crime scene investigations
• Use micropipettes in a Pipetting-by-Numbers™ activity to compare fingerprints
• Reveal the correct fingerprint match under UV or blue light
• Recreate and study blood spatter patterns using transfer pipets
• Investigate how height and force affect blood droplet shape
The Science Behind Finding a Perfect Match: Blood Typing for Stem Cell Transplants
In this experiment, students will take on the role of transplant physicians. They will analyze simulated blood samples for transplant compatibility and compare genetic markers to identify which donor is the best match for a leukemia patient in need of a stem cell transplant.
• Students will analyze simulated blood samples using real world techniques utilized in biomedical labs
• Learn to count white blood cells using a hemocytometer
• Perform blood compatibility tests to reveal information about donor blood samples
• Determine who is the best candidate to donate stem cells to patient in need


Reeling in the Truth: Identifying Red Snapper using Genetic Analysis
In this experiment, students will explore the genetic diversity of fish species in a simulated DNA barcoding experiment. Students will extract DNA from simulated fish samples and use PCR to amplify three gene regions that are conserved between species.
• Learn how to extract DNA from simulated fish samples and amplify specific gene regions using PCR.
• Understand how conserved gene regions can be used to identify species and study genetic diversity.
• Explore DNA barcoding, a critical tool in species identification and conservation biology.
From Field to Flask: Investigating Nitrogen’s Impact on Waterways
Nitrogen is essential for all life on Earth – it’s a key part of DNA, proteins, and the food we eat. In this experiment, students will explore sources of nitrogen in our environment by testing samples for nitrates and nitrites using the Griess reagent. Students will create a standard curve to calculate the concentrations of samples with unknown amounts of nitrate and nitrite.
• Use simple colorimetric methods to detect and measure nitrate levels in real or simulated water samples.
• Explore how fertilizer runoff contributes to eutrophication and related health concerns.
• Interpret nitrate results and propose solutions to reduce nutrient pollution.
• This project was made possible by a Science Education Partnership Award (SEPA), Grant Number 2R44GM143977-02, from the National Institute of General Medical Sciences (NIGMS) of the National Institutes of Health (NIH).


Silent Signals: Tracking Disease Through PCR Wastewater Testing
Wastewater testing is a valuable public health tool that allows scientists to monitor specific diseases within a community. In this experiment, students will use PCR and electrophoresis to analyze simulated water samples for the presence of bacteria and viruses. By exploring how wastewater monitoring works, students will gain insight into how biotechnology plays a vital role in protecting public health.
• Students analyze simulated water samples using PCR and electrophoresis to investigate real-world wastewater surveillance.
• Engaging, hands-on experience with essential biotechnology tools to detect and identify pathogens.
• Illustrates how wastewater testing provides early detection of outbreaks and supports public health decision-making.
• This project was made possible by a Science Education Partnership Award (SEPA), Grant Number 2R44GM143977-02, from the National Institute of General Medical Sciences (NIGMS) of the National Institutes of Health (NIH).
Forensic Escape Room: Design Your Own Biotech Adventure
Explore the world of forensic science with this fun and exciting crime scene escape room! In this investigation, students decipher clues, solve puzzles, and unravel the evidence to free the innocent. Hands-on techniques include forensic blood detection, blood typing, and DNA fingerprinting. Comprehensive instructions on how to set up an escape room are included.
• Students analyze evidence using real-world forensic science techniques, like DNA analysis and blood typing, to prove a suspect’s innocence in this immersive scenario.
• Students gain experience with biotechnology skills, including micropipetting, blood typing, and agarose gel electrophoresis.
• The sequence of experiments supports critical thinking, collaboration, and application of scientific practices, such as data collection and analysis, in a way that aligns with NGSS high school life science performance expectations.


Follow That Flush: Using Biotechnology to Stop Outbreaks
Wastewater testing is a public health tool that helps scientists track specific diseases in a community. In this experiment, students use electrophoresis to test simulated water samples for bacteria and viruses. By learning how wastewater monitoring works, students see how biotechnology helps protect public health.
• Students simulate real-world disease surveillance by analyzing wastewater for Norovirus and E. coli using gel electrophoresis.
• Hands-on use of core biotech tools to detect and identify pathogens in simulated water samples.
• Demonstrates how wastewater testing gives early warnings of outbreaks and informs public health responses.
• This project was made possible by a Science Education Partnership Award (SEPA), Grant Number 2R44GM143977-02, from the National Institute of General Medical Sciences (NIGMS) of the National Institutes of Health (NIH).
Aquatic Detectives: Solve the Mystery of the Contaminated Waterway
Water pollution has wide-reaching impacts on both wildlife and human populations. Contamination can enter the water supply from factories that discharge waste directly into a body of water. In this experiment, students will test simulated water samples to determine what contamination is present, and which factories contribute.
• Introduce students to the importance of clean water for aquatic and terrestrial ecosystem diversity
• Perform water quality investigations to determine the site of water pollution
• Discuss real world problems and identify solutions


Genetic Flightplan: Navigating Galapagos Finch Diversity
The objective of this experiment is to investigate the genetic basis of beak size variation in Galapagos finches before and after a drought event using Restriction Fragment Length Polymorphism (RFLP) analysis. By analyzing DNA samples collected from finches with different beak sizes, students determine the association between specific genetic variations and variations in beak size. This allows students to explore the role of natural selection in shaping beak morphology, providing insights about evolution at the genetic level.
• Introduces PCR-RFLP analysis to analyze specific nucleotide sequences
• Understand how electrophoresis separates differently-sized molecules
• Perform agarose gel electrophoresis
• Meets NGSS HS DCI LS1.A, LS3.A and LS3.B, through the discussion of the structure and function of DNA and heredity and variance of traits.
Code Breakers: Using CRISPR to Rewrite Genetics
Unlock the exciting world of gene editing and investigate the incredible power of CRISPR technology right from your classroom! In this experiment, students explore cutting-edge genetic engineering using CRISPR-Cas9 to knock out the purple chromogenic genes in classroom safe bacteria. Additionally, students test the specificity of CRISPR-Cas9 first hand by using a non-specific CRISPR gRNA templates and analyzing the results.
• Explore genetic engineering, CRISPR, and the central dogma of molecular biology in this comprehensive experiment.
• Transform classroom-safe E. coli with CRISPR RNA templates to test the targeting specificity of the technology.
• Identify successful gene knockout based on the color of the cells.